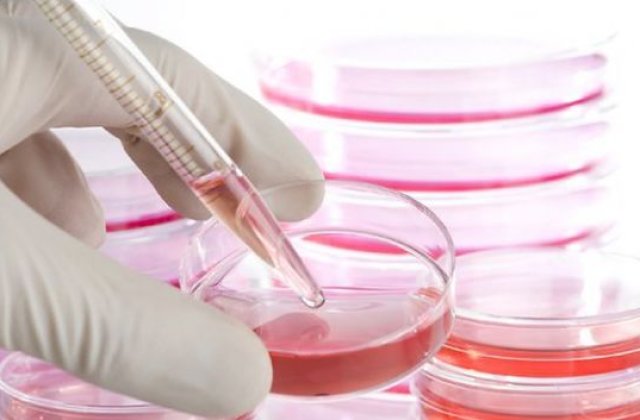
Pacientii romani pot avea acces la celule stem donate de voluntari din strainatate

Executivul a aprobat, miercuri, plata cotizatiilor si taxelor aferente anului 2016 pentru interconectarea institutiilor specializate din Romania cu institutii similare internationale in domeniul donatorilor voluntari de celule stem hematopoietice, in valoare totala de 7.547 euro. Suma alocata se asigura de la bugetul de stat, in cadrul bugetului aprobat Ministerului Sanatatii, informeaza Guvernul printr-un comunicat, citat de MEDIAFAX.
Potrivit documentului, cotizatiile si taxele pentru interconectarea cu institutii similare internationale pentru anul in curs sunt: cotizatia de membru a Asociatiei Mondiale a Donatorilor de Maduva (AMDM), 1.500 euro, cotizatia de membru al organizatiei Donatori de Maduva Osoasa de Pretutindeni (DMOP), 2.897 euro, cotizatia de membru al Grupului European pentru Sange si Transplant de Maduva (GESTM), 900 de euro si taxa pentru acreditarea de catre Federatia Europeana de Imunogenetica a laboratoarelor de imunogenetica si histocompatibilitate, cate 750 de euro pentru fiecare din cele trei laboratoare acreditate.
"Cotizatiile si taxele la care face referire hotararea de guvern aprobata astazi sunt aprobate anual si se calculeaza pe baza cursului de schimb lei/euro stabilit de Banca Nationala a Romaniei la data efectuarii platii. Plata lor se face de catre Registrul National al Donatorilor Voluntari de Celule Stem Hematopoietice, conform HG 760/2009 privind infiintarea registrului. Acreditarea de catre Federatia Europeana de Imunogenetica (FEI) a laboratoarelor HLA (human leukocyte antigen) care indeplinesc standardele europene se face pentru o perioada de un an si numai dupa plata cotizatiilor si a taxei de acreditare", se mai arata in documentul citat.
Despre autor:
Te-ar putea interesa si:
In lipsa unui acord scris din partea Internet Corp, puteti prelua maxim 500 de caractere din acest articol daca precizati sursa si daca inserati vizibil linkul articolului.
Mai multe despre
-

Ce planuri are PKO Bank în România: cea mai mare bancă din Polonia are active...
Sursa: futurebanking.ro
-

Sumă record cheltuită de utilizatorii OnlyFans în 2024. Câți bani au ajuns la...
Sursa: wall-street.ro
-

ANALIZĂ VIDEO Primele produse tehnologice sunt mai mereu proaste
Sursa: start-up.ro
-

Paște 2026: cât costă un cozonac plin cu de toate, în București
Sursa: retail.ro
-

Cine sunt speakerii Green Forum 2026: Cum finanțăm?
Sursa: green.start-up.ro
-

Horoscop săptămânal: Care este ziua ta norocoasă în funcție de zodie în...
Sursa: garbo.ro
-

Choupette, pisica milionară care a primi 1,5 milioane de dolari de la Karl...
Sursa: kudika.ro